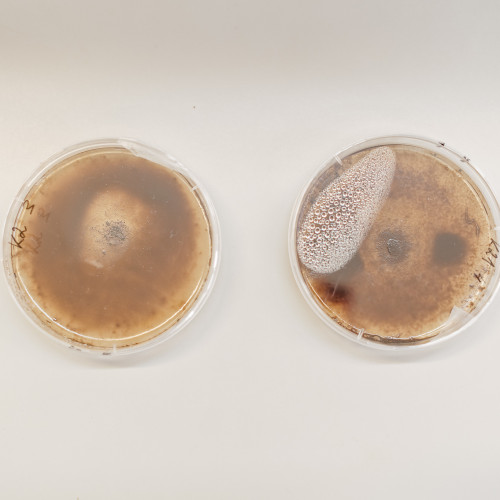
no-show

Išradimas, gimęs KU laboratorijose sujungus technologijų mokslo ir biologijos žinias, sėkmingai išbandytas ir atskleidęs didelį potencialą jį pritaikyti praktikoje, praėjusių metų pabaigoje oficialiai registruotas Europos Sąjungoje bendrojoje patento sistemoje. Tai užtikrina išradimo apsaugą 20 metų net 17–oje ES šalių. Pasak vienos iš šios inovacijos kūrėjų dr. Tatjanos Paulauskienės, tai svarbus etapas rengiant biotechnologiją rinkai – intelektinės nuosavybės apsauga mokslinei idėjai suteikia išskirtinumo, taip lengviau pritraukti investicijas ir įgyti pranašumą rinkoje.
Patentavimo ES erdvėje procedūra biotechnologiją kuriančiai komandai užtruko daugiau nei trejus metus. Paraiška tam pateikta 2020 metų rugsėjo 25-ąją.
„Džiaugiamės, kad bendradarbiavimas apjungiant technologijų ir biologijos kompetencijas pasibaigė patentu, kuris patvirtina, kad judame teisinga ir aktualia kryptimi. Tai paspirtis mūsų tolimesniems darbams šioje srityje, siekiant kurti technologijas, prisidedančias prie švaresnės mus supančių vandenų aplinkos“,- sėkmingai pasibaigusiu išradimo patentavimu ES erdvėje pasidžiaugė dr. Marija Kataržytė.
Lietuvoje ši biotechnologija buvo patentuota dar 2020 metais.
KU atžalinė įmonė „Inobiostar“, kuri buvo sukurta būtent šiai biotechnologijai plėtoti, drauge su KU mokslininkais toliau vykdo mokslinius tyrimus siekdami adaptuoti išradimą dar vienai medžiagai – aerogeliui. Iki tol mokslininkų eksperimentai buvo atliekami su pigiu ir natūraliu žemės ūkio produktu – šiaudais, juos hidrofobizuojant ir ant jų paviršiaus paskleidžiant naftą skaidančius mikroorganizmus. „Dabartiname etape siekiame biotechnologiją išbandyti su aerogeliais, nes jie pasižymi dideliu efektyvumu: 1 gramas šios medžiagos gali sugerti iki 50 gramų naftos produktų (rodiklis 5 kartus didesnis nei rinkoje egzistuojančių analogų). Aerogeliai taip pat draugiški aplinkai, jie gali būti naudojami pakartotinai. Medžiaga gaminama iš popieriaus atliekų“,- sako „Inobiostar“ vadovė dr. Tatjana Paulauskienė.
Biotechnologiją plėtojanti komanda rengia paraišką vienai iš „Europos horizonto“ programų tolesniems tyrimams ir eksperimentams finansuoti. Sėkmės atveju planuojama įrengti pilotinę mažos apimties aerogelių gamyklą (show-room), kuri leistų pagaminti daugiau medžiagos tolimesniam testavimui, pradėti šio produkto komercinimą ir (ar) licencijavimą.